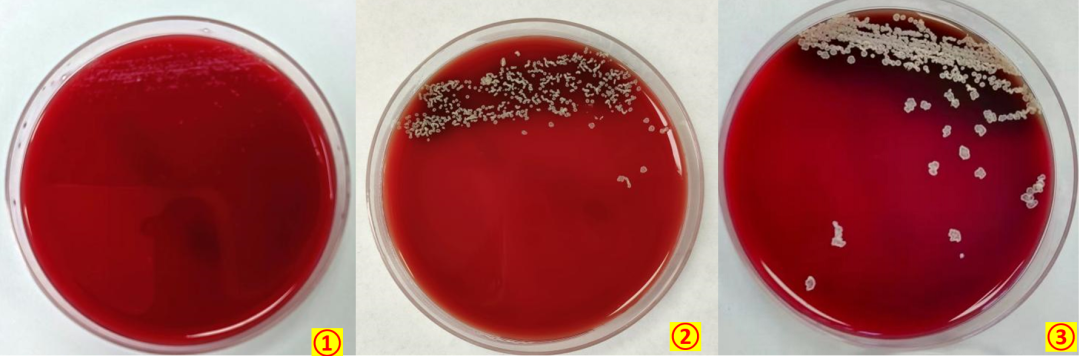

2023-09-13 17:24
作者 卢思吉、潘智玲

京港感染论坛
多学科合作,构建诊断管理体系
诺卡菌广泛分布于土壤等自然界中,多为腐生寄生菌[1],能引起人类急慢性化脓性肉芽肿性变[2],称之为诺卡菌病。诺卡菌病好发于免疫功能低下患者,现分享一例因萜烯诺卡菌引起的全身播散性感染案例。
![]()
▼ 一、病例资料
患者,男,73岁,因“右下肢肿胀1月余,红肿伴溃疡1周”于2023年06月22日入院。
现病史:患者自诉1月余前出现右下肢肿胀,伴左下肢肿胀,伴有解泡沫尿,无明显呼吸困难,尚能行走,伴尿量减少,大便正常,未予特殊处理,1周后出现右下肢红肿,伴疼痛,自行予针灸治疗,未见明显好转,伴皮肤破溃流液,伴行走后气促,到当地医院就诊,查肌酐192μ mol/L↑,白蛋白23.4 g/L↓,谷丙转氨酶97 U/L↑,谷草转氨酶92 U/L↑,BNP 3353 ng/L↑,予抗感染、切开引流处理,未见明显好转,建议转上一级医院治疗,患者为进一步治疗来我院就诊,门诊检查:白细胞计数10.05×109/L↑,中性粒细胞97.8 %↑,淋巴细胞1.0 %↓,血红蛋白浓度109 g/L↓。凝血检测:纤维蛋白原10.76 g/L↑,D-二聚体8.49 μg/mL↑,余正常。C反应蛋白349.33 mg/L↑,胱抑素3.02 mg/L↑,肌酐188.6 μmol/L↑,尿素17.42 mmol/L↑,尿酸397.2 μmol/L,天门冬氨酸氨基转移酶131 U/L↑,乳酸脱氢酶653.9 U/L↑,α-羟基丁酸脱氢酶466.7 U/L↑,肌酸激酶1071.2 U/L↑,肌酸激酶同工酶47.5 U/L↑。门诊拟“脓毒血症”收入我院急诊医学科。
既往史及个人史:无特殊。
体格检查: T 36.7℃ P 80次/分 R 27次/分 BP 95/59 mmHg,双肺呼吸音粗,闻及少许湿性啰音,心界不大,心率169次/分,心律不齐。双下肢肿胀,右下肢红肿,皮温高,触痛,可见3处伤口,放置引流条,局部渗液。
初步诊断:1.脓毒血症(sofa评分3分);2.脓毒性休克3.多器官功能障碍综合征(MODS)(心功能不全、肾功能不全、肝功能不全);4.肝功能不全;5.心功能不全;6.肾功能不全;7.下肢蜂窝织炎;8.快速性心房颤动。
▼ 二、辅助检查
1.心电图:显著快速心室反应性心房颤动,顺钟向转位,电轴左偏。
2.影像学检查
(1)胸部(肺)平扫(64排CT): 1.两肺炎症,左肺下叶支气管闭塞并左肺下叶肺组织实变;两侧胸腔少量积液;请结合临床、治疗后复查,必要时完善增强CT检查除外掩盖病变。2.心腔密度减低,拟贫血征象。3.主动脉硬化。4.右侧第7前肋稍扭曲并密度欠均匀,建议随诊,密切观察病情变化。

▲图(1)2023-6-22胸部(肺)平扫(64排CT)
(2)双下肢血管彩色超声检查:左大腿内侧下段及小腿外侧上段皮下异常声像,脓肿?请结合临床,目前双股静脉、腘静脉未见明显血栓形成。
3.实验室检查
血常规:白细胞计数8.35×109/L,红细胞计数3.22×1012/L↓,血红蛋白浓度99 g/L↓,血小板计数196×109/L。凝血检测:纤维蛋白原11.68 g/L↑,余正常。心肌酶谱五项:乳酸脱氢酶403.7 U/L↑,α羟基丁酸脱氢酶316.9 U/L↑,余正常。肝功:天门冬氨酸氨基转移酶128 U/L↑,间接胆红素10.3 μmol/L↑,总蛋白 47.9 g/L↓,白蛋白 23.9 g/L↓,余正常。空腹血糖 6.7 mmol/L。糖化血红蛋白7.2 %↑。肾功能四项:胱抑素2.70 mg/L↑,肌酐145.3 μmol/L↑,尿素33.94 mmol/L↑,余正常。入院后多次查CRP,变化趋势如下(如图2)。降钙素原15.829 ng/mL↑。介素-6测定1180.17 pg/ml↑。CD64感染指数:CD感染指数42.12↑,粒细胞百分率98.7↑。真菌D-葡聚糖<10.00 pg/ml,革兰阴性菌脂多糖<5.00 pg/ml。BNP 106.5 pg/L。

▲图(2)C—反应蛋白(参考范围<5㎎/L)变化趋势图
4.微生物检查
(1)血培养:阴性
(2)术中下肢坏死筋膜组织及脓性分泌物(图3) 直接涂片及培养。
术中组织及分泌物直接涂片革兰染色、弱抗酸染色:见革兰阳性长杆菌,可见分枝状菌丝,部分菌丝呈90°角,弱抗酸染色为阳性(图4)。抗酸染色阴性。
(3)术中取坏死筋膜组织、脓性分泌物分离培养:5% CO2、35℃环境下培养3天可见白色不规则凸起菌落,部分菌落中心有凹陷,有泥土气味,有轻微咬琼脂现象(图5),菌落涂片染色可见:革兰阳性长杆菌,可见分枝状菌丝,部分菌丝呈90°角,疑似诺卡菌,经全自动微生物质谱检测系统鉴定该菌为萜烯诺卡菌。(图6)

▲图(3)术中组织及脓性分泌物

▲图(4)①直接涂片革兰染色×1000 ②直接涂片弱抗酸染色×1000 ③菌落革兰染色×1000
▲图(5)①血琼脂平板培养 1天 ②血琼脂平板培养 2天 ③血琼脂平板培养 5天

▲图(6)全自动微生物质谱仪结果
(4)痰培养(图7):亦检出萜烯诺卡菌

▲图(7)①痰液标本 ②血琼脂平板培养 3天 ③菌落革兰染色×1000
▼ 三、诊疗经过
6月22日:患者因右下肢肿胀1月余,红肿伴溃烂1周入院,请多学科会诊后指出患者肌钙蛋白高,呼吸、心脏功能不全等考虑与感染相关,不能排除肾病综合征,加强抗感染、补充白蛋白治疗;快房颤予以西地兰控制心率;行右下肢伤口感染的引流清创术,术中可见右足背、右小腿肿胀明显可见三处切口,于右足背、右小腿分别做切口,切开皮肤、皮下筋膜层,可见大量脓液积聚,筋膜坏死,钝性分离筋膜间可见大量脓液涌出,切除部分坏死筋膜组织和脓液做细菌培养,术程顺利,术后转入ICU,给予哌拉西林钠他唑巴坦钠抗感染治疗。
6月23日:患者因循环不稳定,术前合并肺部感染,炎症指标明显升高,合并多器官功能障碍,经抗菌专家小组讨论后,考虑脓毒血症、脓毒性休克,给予美罗培南抗感染治疗。
6月25日:患者皮肤组织感染重,下肢脓肿坏死,软组织广泛坏死,随时可能有截肢风险,再次行下肢伤口感染的清创术,同时微生物室回报术中坏死筋膜组织及脓性分泌物培养、痰培养结果为萜烯诺卡菌感染,根据诺卡菌的相关药敏资料调整为美罗培南+复方磺胺甲噁唑抗感染治疗。
6月27日:由于病情发展迅速,四肢多处脓肿形成,蜂窝织炎形成,卡率脓肿形成,感染重,家属放弃治疗,经沟通,准予出院。
▼ 四、案例分析
诺卡菌是一种机会性病原体,广泛分布在土壤和水生环境中,可通过空气或接触传播,呼吸道传播是诺卡菌进入体内最常见的传播方式,因此肺部诺卡菌感染最为常见,临床常表现为咳嗽,咳痰,发热等,症状与肺结核相似,要注意与结核分枝杆菌的区别。此外,诺卡菌可因外伤、手术等引起外源性感染,导致皮肤红肿、溃烂等,在各年龄可能都会发病,但发病率老年男性居高。诺卡菌还可经血液循环播散至中枢神经系统引起恶心、呕吐、头痛等临床表现[3]。
在本案例中,患者因“右下肢肿胀1月余,红肿伴溃疡1周”入院,初步诊断为脓毒血症、脓毒性休克、肺部感染、右下肢感染合并多器官功能障碍,入院前诊疗经过不详,故无法评估病原体的入侵途径,但患者痰培养检出萜烯诺卡菌,患者自诉行走后气促,影像学提示肺部感染,先后两次取术中坏死筋膜组织及脓性分泌物培养均检出萜烯诺卡菌,结合临床表现及相关辅助检查,不除外通过皮肤接触诺卡菌或呼吸道吸入诺卡菌引起传播,进而引起全身播散性感染,最终导致脓毒血症、脓毒性休克、肺部感染、右下肢感染合并多器官功能障碍。据文献报道,血培养送检一次的病原体阳性检出率仅为65%,而两次送检的病原体阳性检出率可达80%,3次送检的病原体阳性检出率更高达96%,所以正确的采血次数、充足的采血量、适当的采集时间对于血培养检测至关重要[4]。该患者入院后出现脓毒血症、脓毒性休克,入院后送检血培养一次,结果为阴性,而患者全身多组织器官感染诺卡菌,对于此类患者应采集多份血培养,并适当延长培养时间,以提高病原体检出率。
萜烯诺卡菌为临床少见菌,美国临床和实验室标准化协会(CLSI)推荐诺卡菌和其他需氧放线菌药敏试验方法是肉汤微量稀释法[5],目前我实验室未常规开展此菌的药敏试验。临床先后给予哌拉西林钠他唑巴坦钠,美罗培南+复方磺胺甲噁唑抗感染治疗,复查炎症指标稍前下降,仍明显偏高,抗感染效果欠佳。根据相关文献报道,复方磺胺甲噁唑是治疗诺卡菌感染的首选药物[6],此外,诺卡菌对利奈唑胺、亚胺培南、阿米卡星等药物多为敏感,目前临床医生根据经验得出诺卡菌的药物治疗推荐三联用药,即复方磺胺甲噁唑、阿米卡星和头孢曲松钠或亚胺培南[7]。
▼ 五、案例总结
由于诺卡菌感染无临床特异性表现,确诊方式主要依赖于病原学检查[8],细菌培养、质谱鉴定及基因测序是诊断诺卡菌感染的金标准。此病例患者痰液和术中组织及分泌物培养及涂片均检出萜烯诺卡菌,由此可明确该患者是由萜烯诺卡菌引起的全身播散性感染。患者在当地医院就诊时未能检出病原菌,在感染初期未能及时得到诊治,导致了治疗延误,转来我院时已经错过了最佳治疗时间,治疗难度大,最后患者放弃治疗。当患者出现皮肤、肺部等部位感染,普通抗感染药物治疗效果不佳时,应考虑诺卡菌病感染的可能。此案例也警示着我们,在以后的工作中,要提高对该菌的认识及检测能力,避免对该菌的漏检,为临床疾病的早期诊断与治疗提供帮助。
参考资料(上下滑动)
[1]吴建玲,江艳萍,黄振东等.肺诺卡菌病合并皮下脓肿2例报道[J].福建医科大学学报,2022,56(05):438-443.
[2]刘洋,朱伦刚,黄彬等.星形诺卡菌肺部感染1例并文献复习[J].传染病信息,2022,35(02):186-190.
[3]乔景绍,谷千山,攸力等.诺卡菌脑脓肿破入脑室一例并文献复习[J].磁共振成像,2022,13(04):139-140.
[4]周思妍. 以LAMP-CRISPR/Cas12a为基础的儿童呼吸道病原检测方法的建立与应用[D].吉林大学,2023.DOI:10.27162/d.cnki.gjlin.2023.002973.
[5]周传奇,夏建朴,时东彦.圣乔治诺卡菌致义眼台感染1例[J].临床检验杂志,2020,38(03):239-240.DOI:10.13602/j.cnki.jcls.2020.03.20.
[6]安袁笑雪. 肺诺卡菌感染临床特征、药物选择及预后不良因素分析[D].山东大学,2022.DOI:10.27272/d.cnki.gshdu.2022.001098.
[7]余方颖,胡权铖,刘璐璐等.肺部豚鼠耳炎诺卡菌感染一例并文献复习[J].中国呼吸与危重监护杂志,2022,21(03):200-204.
[8]熊洁,任小平,任亚娟等.老年慢性阻塞性肺疾病并肺诺卡菌感染9例临床分析[J].临床肺科杂志,2020,25(02):218-222.
▲点击图片,关注2023京港年会

卢思吉
主管技师,就职于广西柳州市柳江区妇幼保健院,从事检验工作12年,目前在柳州市人民医院检验科微生物组进修。

潘智玲
就职于柳州市人民医院,副主任技师,从事临床检验工作11余年,以课题负责人承担市厅级课题一项,柳州市人民院内课题一项。

指导老师:罗柳春
就职于柳州市人民医院,副主任技师,从事临床微生物检验工作10余年,任微生物专业组组长,2017年9月至2018年2月在北京大学人民医院进修,以课题负责人承担市厅级课题两项。
END
作者|卢思吉1(进修) 潘智玲2
指导|罗柳春 柳州市人民医院检验科
单位|1柳州市柳江区妇幼保健院 2柳州市人民医院检验科
审校|王占伟(北京大学人民医院)

